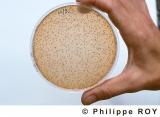

Vous pouvez utiliser les opérateurs ET, OU et SAUF entre les mots de votre recherche.
Image 33V41629.jpg
33V41629.jpg
MICROBIOLOGIE, SOCIETE LAFFORT, FLOIRAC, GIRONDE.
RECHERCHE ET DEVELOPPEMENT EN MICROBIOLOGIE , ANALYSE MICROBIOLOGIQUE AU BEC BENZENE ET BOITE DE PETRI POUR DETECTER LA DIFFERENCE ENTRE UN VIN ENSEMENCE ET UN VIN NON ENSEMENCE, LABORATOIRE D' OENOLOGIE , SOCIETE LAFFORT , FLOIRAC, GIRONDE,...
phroy.photo@wanadoo.fr
|
|
33V41629.jpg |
Image 33V41631.jpg
33V41631.jpg
MICROBIOLOGIE, SOCIETE LAFFORT, FLOIRAC, GIRONDE.
RECHERCHE ET DEVELOPPEMENT EN MICROBIOLOGIE , ANALYSE MICROBIOLOGIQUE AU BEC BENZENE ET BOITE DE PETRI POUR DETECTER LA DIFFERENCE ENTRE UN VIN ENSEMENCE ET UN VIN NON ENSEMENCE, LABORATOIRE D' OENOLOGIE , SOCIETE LAFFORT , FLOIRAC, GIRONDE,...
phroy.photo@wanadoo.fr
|
|
33V41631.jpg |
Image 33V41630.jpg
33V41630.jpg
MICROBIOLOGIE, SOCIETE LAFFORT, FLOIRAC, GIRONDE.
RECHERCHE ET DEVELOPPEMENT EN MICROBIOLOGIE , ANALYSE MICROBIOLOGIQUE AU BEC BENZENE ET BOITE DE PETRI POUR DETECTER LA DIFFERENCE ENTRE UN VIN ENSEMENCE ET UN VIN NON ENSEMENCE, LABORATOIRE D' OENOLOGIE , SOCIETE LAFFORT , FLOIRAC, GIRONDE,...
phroy.photo@wanadoo.fr
|
|
33V41630.jpg |
Image 00E00423.jpg
00E00423.jpg
Laboratoire d'analyse
REPIQUAGE DES SALMONELLES, LABORATOIRE DEPARTEMENTAL DES LANDES, MONT DE MARSAN, LANDES, AQUITAINE, FRANCE Repiquage des salmonelles Mont de Marsan - 40 - Landes [pas d'autorisation nécessaire]
phroy.photo@wanadoo.fr
|
|
00E00423.jpg |
Image 00E00419.jpg
00E00419.jpg
Laboratoire d'analyse
ISOLEMENT DES SALMONELLES, LABORATOIRE DEPARTEMENTAL DES LANDES, MONT DE MARSAN, LANDES, AQUITAINE, FRANCE Isolement des salmonelles Mont de Marsan - 40 - Landes [pas d'autorisation nécessaire]
phroy.photo@wanadoo.fr
|
|
00E00419.jpg |
Image 00E00408.jpg
00E00408.jpg
Laboratoire d'analyse
ENSEMENCEMENT MICROBIOLOGIQUE D' ECHANTILLONS DE GRAS, LABORATOIRE DEPARTEMENTAL DES LANDES, MONT DE MARSAN, LANDES, AQUITAINE, FRANCE Lecture des milieux de culture, ensemencement microbiologique d'échantillons de gras Mont de Marsan - 40 -...
phroy.photo@wanadoo.fr
|
|
00E00408.jpg |
Image 00E00407.jpg
00E00407.jpg
Laboratoire d'analyse
ENSEMENCEMENT MICROBIOLOGIQUE D' ECHANTILLONS DE GRAS, LABORATOIRE DEPARTEMENTAL DES LANDES, MONT DE MARSAN, LANDES, AQUITAINE, FRANCE réaction des germes en boîte de pétri, ensemencement microbiologique d'échantillons de gras Mont de Marsan...
phroy.photo@wanadoo.fr
|
|
00E00407.jpg |
Image 00A01240.jpg
00A01240.jpg
Agriculture
LABORATOIRE D ANALYSE, AGRICULTURE, GIRONDE, AQUITAINE, FRANCE - Service vétérinaire, comptage du développement bactériologique de la viande en boîte de Pétri - Bordeaux - 33 - Gironde - [Pas d'autorisation nécessaire]
phroy.photo@wanadoo.fr
|
|
00A01240.jpg |
Image 00A00630.jpg
00A00630.jpg
Laboratoire
AGROALIMENTAIRE, CONTROLE SANITAIRE, LABORATOIRE D ANALYSE, FRANCE - Analyse des services vétérinaires - Contrôle du développement bactériologique de viande en boîte de Pétri - - [Pas d'autorisation nécessaire]
phroy.photo@wanadoo.fr
|
|
00A00630.jpg |
Image 33V02931.jpg
33V02931.jpg
Oenologie - Vin de Bordeaux
CULTURE DE LEVURE POUR FERMENTATION, OENOLOGIE, CHAMBRE D'AGRICULTURE DE BORDEAUX, VIGNOBLE DU BORDELAIS, GIRONDE, FRANCE - Culture de levure pour fermentation du jus de raisin. - - Chambre d'Agriculture de la Gironde - Bordeaux - 33 - Gironde -...
phroy.photo@wanadoo.fr
|
|
33V02931.jpg |
Image 33V02929.jpg
33V02929.jpg
Oenologie - Vin de Bordeaux
ETUDE SUR LE BOTRYTIS CINEREA, FACULTE D'OENOLOGIE, BORDEAUX, GIRONDE, FRANCE - Etude sur le développement du botrytis cinerea dans des boîtes de pétri, pour l' élaboration des vins blanc liquoreux ( Sauternes) ,faculté d'oenologie . - Bordeaux -...
phroy.photo@wanadoo.fr
|
|
33V02929.jpg |
Image 33V02826.jpg
33V02826.jpg
Oenologie - Vin de Bordeaux
LOUPE BINOCULAIRE, MICROBIOLOGIE, LABORATOIRE D'OENOLOGIE, SOUSSAC, VIGNOBLE DU BORDELAIS, GIRONDE, FRANCE - Contrôle à la loupe binoculaire. Laboratoire d'oenologie de la Chambre d' agriculture de la gironde. - Soussac - 33 - Gironde - [pas...
phroy.photo@wanadoo.fr
|
|
33V02826.jpg |

English version